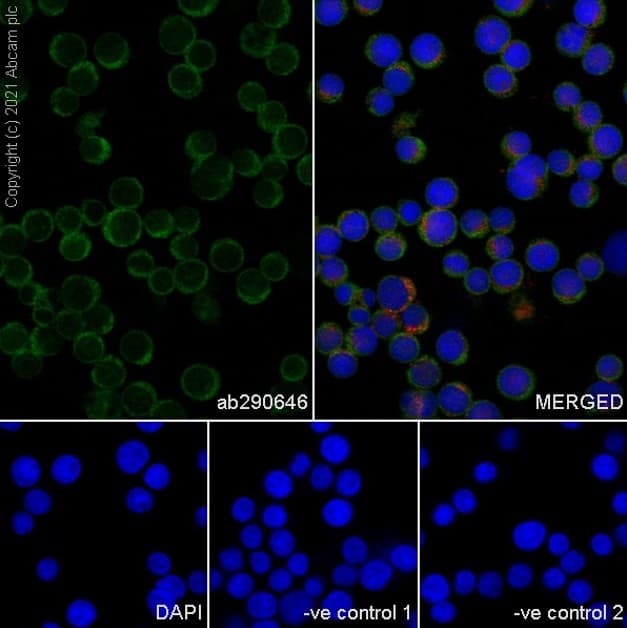
Goat Anti-Mouse IgG H&L (Alexa Fluor® 488) preadsorbed(AB150117)

Goat Anti-Mouse IgG H&L (Alexa Fluor® 488) preadsorbed(AB150117)
$undefined

| Shipped At Conditions | Blue Ice |
| Appropriate Long term Storage Conditions | Store at -20°C. |
| Clonality | Polyclonal |
| Applications | ELISA, Flow Cyt, ICC/IF, IHC-Fr, IHC-P |
| Isotype | IgG |
| Conjugation | Alexa Fluor® 488 |
| CAS Number | Heavy & Light chains |